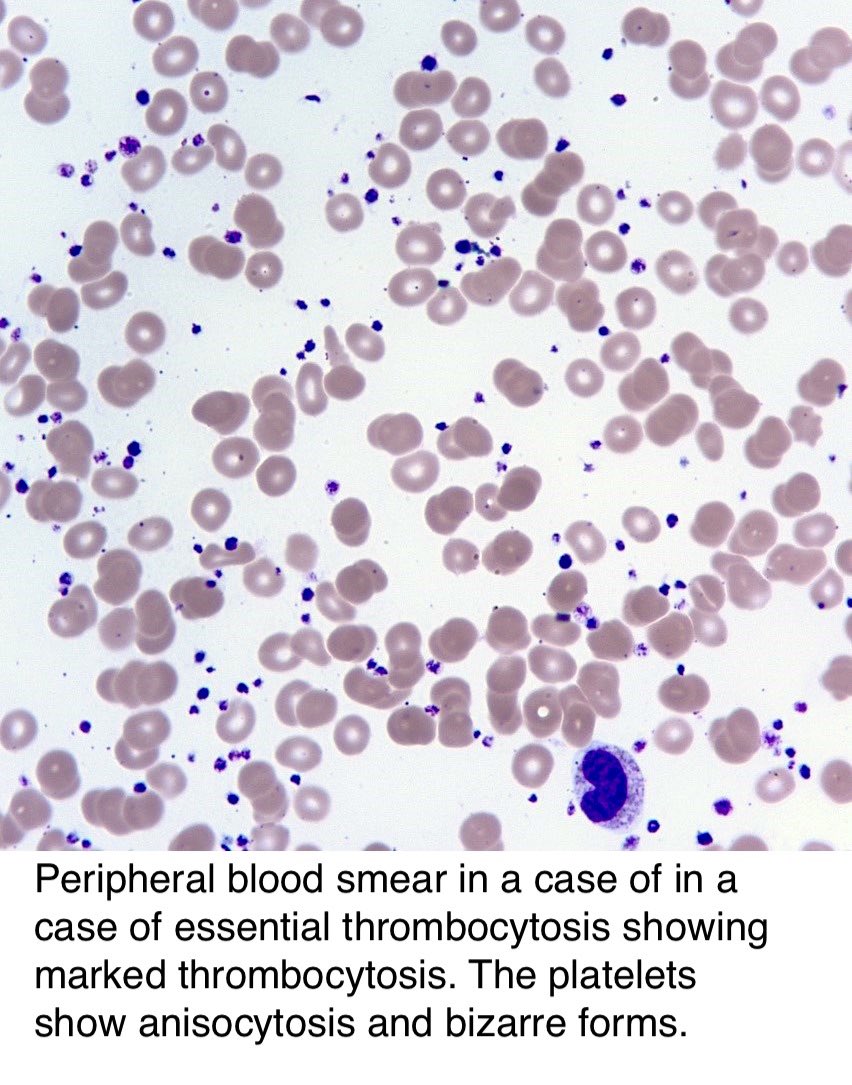

✨ في هذا الثريد راح أتكلم عن الـ Essential Thrombocytosis من ناحية التعريف، الاسباب، عوامل الخطورة، الاعراض، ولا ننسى التشخيص والعلاج 👌🏻
راح أعطيكم فكرة عامه عنه 👍🏻
راح أعطيكم فكرة عامه عنه 👍🏻
بشكل عام الاغلبية المصابين فيه يعيشون حياتهم طبيعية اذا كان فيه مراقبة لحالتهم الصحية بشكل مستمر 👍🏻
في جزء بسيط منهم ممكن تحدث معه المضاعفات
في جزء بسيط منهم ممكن تحدث معه المضاعفات
✏️ الاسباب:
⁃ لحد الان للاسف الاسباب غير معروفة، 90 % من المصابين عندهم طفرة جينية.
⁃ لحد الان للاسف الاسباب غير معروفة، 90 % من المصابين عندهم طفرة جينية.
✏️ عوامل الخطورة:
⁃ المرأة مُعرضة للاصابة فيه أكثر من الرجل 👍🏻
⁃ ما فوق سن الـ 60 مُعرضين أكثر على الرغم أيضاً من إن 20% من المصابين تحت سن الـ 40 👍🏻
⁃ اللي يشتغلون في بيئة ويتعرضون للمواد الكيميائية أو الكهربائية مُعرضين أكثر للاصابة 👍🏻
⁃ المرأة مُعرضة للاصابة فيه أكثر من الرجل 👍🏻
⁃ ما فوق سن الـ 60 مُعرضين أكثر على الرغم أيضاً من إن 20% من المصابين تحت سن الـ 40 👍🏻
⁃ اللي يشتغلون في بيئة ويتعرضون للمواد الكيميائية أو الكهربائية مُعرضين أكثر للاصابة 👍🏻
✏️ الاعراض:
⁃ صداع/ Headache
⁃ إضطرابات بالرؤية أو صداع نصفي صامت / Vision disturbances or silent migraines
⁃ الدوخة / Dizziness
⁃ برودة بالاطراف / Coldness fingers or
⁃ سهولة حصول الكدمه / Easy bruising
⁃ صداع/ Headache
⁃ إضطرابات بالرؤية أو صداع نصفي صامت / Vision disturbances or silent migraines
⁃ الدوخة / Dizziness
⁃ برودة بالاطراف / Coldness fingers or
⁃ سهولة حصول الكدمه / Easy bruising
✏️ التشخيص:
⁃ صورة دم كاملة / Complete Blood Count - CBC
راح يشوفون عدد الصفائح الدموية. بهذي الحالة راح تكون أعلى من المعدل الطبيعي ⬆️
🌀 المعدل الطبيعي:
من 150,000 الى 450,000 👍🏻
⁃ صورة دم كاملة / Complete Blood Count - CBC
راح يشوفون عدد الصفائح الدموية. بهذي الحالة راح تكون أعلى من المعدل الطبيعي ⬆️
🌀 المعدل الطبيعي:
من 150,000 الى 450,000 👍🏻
⁃ Genetics Test 🧬
نشوف اذا طفرة جينية بـ JAK2 Kinase Enzyme أم لا
نشوف اذا طفرة جينية بـ JAK2 Kinase Enzyme أم لا
▫️ في حالة الـ High Risk
⁃ أدوية تساعد على تقليل كمية الصفائح الدموية
أدوية من الـ Hydroxyurea و Interferon-alpha راح يصرفها الدكتور للمريض عشان يقلل من تصنيع الـ Megakaryocyte داخل نخاع العظم 👍🏻
⁃ أدوية تساعد على تقليل كمية الصفائح الدموية
أدوية من الـ Hydroxyurea و Interferon-alpha راح يصرفها الدكتور للمريض عشان يقلل من تصنيع الـ Megakaryocyte داخل نخاع العظم 👍🏻
وهذا فديو رائع شرحه جميل و يتكلم عن نفس الموضوع 👍🏻
youtu.be
youtu.be
Loading suggestions...